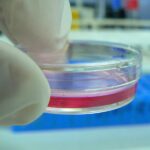
Cultivos in vitro para microbiología

El sistema digestivo es un conjunto de órganos y estructuras encargados de procesar los alimentos que ingerimos, descomponerlos en nutrientes y absorberlos para proporcionar energía y sustancias necesarias para el funcionamiento del cuerpo.
El sistema digestivo ocupa parte de la cabeza, donde se origina, desciende por el cuello, atraviesa las cavidades torácica, abdominal y pelviana y se abre al exterior, algo debajo y delante del cóccix en la región perineal. En este trayecto, el sistema digestivo comprende seis segmentos:
A la descripción precedente deben agregarse las glándulas anexas al sistema digestivo:
- las glándulas salivales
- el hígado
- el páncreas
El sistema digestivo comienza en la boca, donde los alimentos se mastican y se mezclan con la saliva, que contiene enzimas que comienzan a descomponer los carbohidratos. Luego, el alimento pasa por la faringe y el esófago hasta llegar al estómago.
En el estómago, el alimento se mezcla con jugos gástricos que contienen ácido clorhídrico y enzimas digestivas, que descomponen las proteínas y ayudan a matar bacterias presentes en los alimentos. Después de ser procesado en el estómago, el alimento se convierte en una mezcla semilíquida llamada quimo.
El quimo pasa al intestino delgado, donde se mezcla con enzimas digestivas provenientes del páncreas y la vesícula biliar. Aquí se completa la descomposición de los nutrientes en proteínas, carbohidratos y lípidos, los cuales son absorbidos a través de las paredes del intestino delgado y pasan al torrente sanguíneo.
El intestino delgado desemboca en el intestino grueso, donde se absorben agua y sales minerales, y los residuos no digeribles se convierten en heces. Las heces se almacenan en el recto y se eliminan a través del ano durante la defecación.
Además de los órganos principales mencionados, el sistema digestivo también incluye estructuras como el hígado, que produce la bilis necesaria para la digestión de las grasas, y el páncreas, que produce enzimas digestivas y hormonas importantes para el metabolismo de los nutrientes.

Síguenos en X: @el_homomedicus y @enarm_intensivo Síguenos en instagram: homomedicus y en Treads.net como: Homomedicus